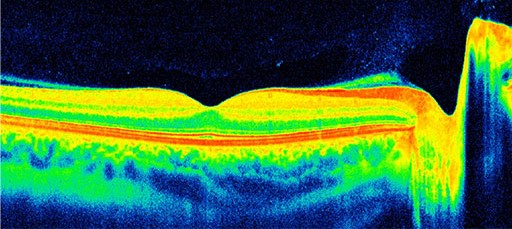

Les centres sont organisés autour de médecins ophtalmologistes très spécialisés en imagerie avec travail en équipes pluridisciplinaires associant les médecins aux orthoptistes et infirmières afin de répondre avec la plus grande efficacité aux demandes d’examens complémentaires prescrits par les ophtalmologistes traitants.
Les centres Explore Vision viennent en complément des explorations déjà disponibles dans les centres de consultation.
Les spécificités des centres Explore Vision sont :
- De proposer les appareils d’examen les plus performants et constamment renouvelés en fonction des évolutions technologiques.
- Et de disposer de la quasi-totalité des explorations existantes que ce soit dans les indications de glaucome, cataracte, rétine et chirurgie réfractive.
Ces plateaux techniques lourds ne peuvent pas être disponibles dans tous les centres de consultation : la grande spécialisation des centres Explore Vision, ayant la confiance de très nombreux ophtalmologistes, a permis depuis de nombreuses années d’étendre la palette des explorations et la grande spécialisation des équipes internes.
Tous les personnels travaillant dans les centres Explore Vision reçoivent une formation très spécialisée afin de maîtriser les différents appareils et les protocoles de chaque technique d’exploration. Par exemple les secrétaires peuvent ainsi organiser au mieux les séquences d’examens lors de la prise des rendez-vous : certains examens nécessitent une dilatation des pupilles et d’autres non ce qui impose un ordre dans la réalisation des explorations. De même les orthoptistes maîtrisent parfaitement les acquisitions d’images par les nombreux appareils et peuvent présélectionner les procédures d’acquisition les mieux adaptées au cas de chaque pathologie.
La haute spécialisation des centres et la lourdeur des plateaux techniques impose une gestion optimale des rendez-vous avec structuration des espaces pour affecter un seul appareil par pièce d’examen. Les locaux sont tous climatisés avec système de renouvellement d’air.
Le bloc d’injection intra-vitréenne respecte les normes des blocs de chirurgie avec un très haut niveau d’asepsie.
Chaque examen donne lieu à un compte rendu qui est adressé par courrier ou par voie électronique au médecin prescripteur.
L’organisation des centres Explore Vision est conçue pour venir en complément des examens réalisés par l’ophtalmologiste traitant. La relation de confiance tissée depuis plus de 15 ans avec les ophtalmologistes, est basée sur le fait que les centre Explore Vision ne pratiquent pas de bilan ophtalmologique classique et ne pratiquent pas de chirurgie avec bloc opératoire.